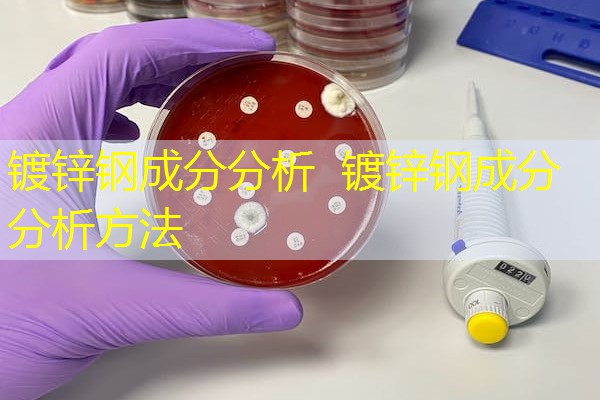

镀锌钢成分分析简介
镀锌钢是一种通过将钢材浸入熔融的锌中,形成一层锌涂层的钢材。镀锌钢具有优异的耐腐蚀性能和良好的外观效果,广泛应用于建筑、汽车、家电等领域。镀锌钢的成分分析是对其化学成分进行检测和分析,以确保其质量和性能。
相关国家标准
在中国,镀锌钢的成分分析需要符合国家标准GB/T 228.1-2010《金属材料拉伸试验 第1部分:室温试验方法》和GB/T 223.5-2008《钢铁及合金化学分析方法 第5部分:低碳钢和中碳钢的氧化物分析法》等相关标准。
国外标准
国外对于镀锌钢的成分分析也有一些相关标准,如美国标准ASTM A370-19《Standard Test Methods and Definitions for Mechanical Testing of Steel Products》和欧洲标准EN 10002-1:2001《Metallic materials - Tensile testing - Part 1: Method of test at ambient temperature》等。
服务流程

镀锌钢成分分析的服务流程一般包括以下几个步骤:
- 样品采集:从生产线上或现场采集镀锌钢样品。
- 样品制备:将采集到的样品进行预处理,如切割、研磨等。
- 化学分析:使用化学分析方法对样品进行成分分析,包括主要元素和杂质元素的含量。
- 数据处理:对分析结果进行统计和分析,生成测试报告。
- 结果评估:根据测试报告评估镀锌钢的成分是否符合标准要求。
检测或认证项目介绍
镀锌钢成分分析的检测或认证项目主要包括以下几个方面:
- 主要元素含量:对镀锌钢中的主要元素如铁、碳、锌等进行定量分析。
- 杂质元素含量:对镀锌钢中的杂质元素如硫、磷、铜等进行定量分析。
- 金属相组成:通过金相显微镜等方法对镀锌钢的金属相组成进行观察和分析。
- 机械性能测试:对镀锌钢进行拉伸、弯曲等机械性能测试,评估其强度、韧性等性能。
- 耐腐蚀性能测试:对镀锌钢进行盐雾试验、湿热试验等耐腐蚀性能测试。
相关费用
镀锌钢成分分析的费用根据不同的实验室和项目而有所差异。一般来说,成分分析的费用包括样品制备费用、化学分析费用、数据处理费用和测试报告费用等。具体的费用可以咨询实验室或检测机构进行了解。